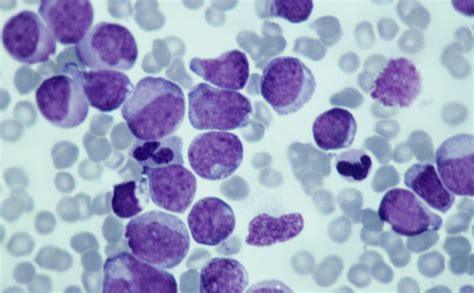
cellule tumorali al microscopio

Il melanoma congenito melanocitico gigante è una condizione rara e complessa che colpisce un bambino ogni 50.000 nati. Si manifesta come una vasta macchia scura sulla pelle, presente fin dalla nascita, che cresce insieme al bambino. La gestione di questa patologia rappresenta una sfida significativa, richiedendo interventi chirurgici multipli e un costante monitoraggio. Le storie di Giada Bortolotto, una bambina di quattro anni affetta da questa condizione, e di una giovane donna che ha affrontato un melanoma diagnosticato in età adulta, offrono uno sguardo profondo sulle difficoltà, le speranze e le complessità legate a questa malattia.
La Battaglia di una Bambina: Giada Bortolotto e il Melanoma Congenito Gigante
A Trissino, in provincia di Vicenza, vive una bambina di nome Giada, di soli quattro anni. La sua vita, pur essendo quella di una bambina vivace e socievole, è segnata dalla lotta contro un enorme melanoma congenito melanocitico gigante. Questa condizione, che copre tre quarti del suo corpo - schiena, fianco destro e pancia - è una malattia rara che richiede un approccio terapeutico esclusivamente chirurgico. La madre, Alessandra Faggion, racconta con commozione le sfide affrontate fin dalla nascita di Giada.

La diagnosi iniziale, avvenuta all'ospedale di Arzignano, non fu semplice, trattandosi del primo caso di questo tipo riscontrato dai medici. La scarsa informazione sulle malattie rare ha reso il percorso ancora più arduo. A soli tre mesi di vita, Giada ha sviluppato dei noduli sulla schiena, spingendo la famiglia a cercare supporto online. Un'associazione di famiglie con bambini affetti da patologie simili li ha indirizzati all'ospedale Bambin Gesù di Roma, dove Giada ha iniziato il suo percorso chirurgico con i primi tre interventi. Successivamente, grazie al contatto tra il medico romano e il dottor Maurizio Pegoraro della Chirurgia Plastica del San Bortolo di Vicenza, gli interventi sono proseguiti più vicino a casa, un aspetto logistico ed economico di inestimabile valore per la famiglia.
Le continue trasferte a Roma hanno rappresentato un onere finanziario considerevole per la famiglia Bortolotto. Alessandra, titolare di un salone di parrucchiera ed estetica, e il marito, operaio, hanno dovuto affrontare spese ingenti, al punto da dover sospendere per un anno il pagamento del mutuo. "Giada ha la precedenza su tutto, il melanoma va eliminato", spiega la madre, con la preoccupazione che il tumore, attualmente benigno, possa cambiare natura. È fondamentale anche tenere sotto controllo i melanomi satelliti, più piccoli, che possono comparire in altre parti del corpo, come testa, gambe e glutei. La serenità per la famiglia arriverà solo quando la vasta area interessata dal melanoma sarà completamente rimossa, un processo che ha visto la schiena di Giada quasi completamente liberata.
Le procedure chirurgiche sono complesse e dolorose. Per ottenere lembi di cute sana, vengono inseriti sottopelle dei palloncini che vengono gonfiati settimanalmente per circa cinque mesi, aumentando l'elasticità della pelle. Successivamente, la pelle così preparata viene utilizzata per coprire le aree malate, precedentemente asportate. Nonostante il dolore e il disagio, Giada dimostra una notevole sopportazione. "Giada ha una buona sopportazione", aggiunge la mamma, "ormai è abituata a entrare e uscire dagli ospedali e adesso inizia a capire. Le abbiamo mostrato le foto di quando era più piccola e ha visto com’è cambiata. Non l’abbiamo mai isolata, abbiamo scelto di iscriverla all’asilo per farla stare in mezzo agli altri bambini, ai quali lei mostra i suoi palloncini sottopelle, disinvolta. Le maestre stanno attente a evitare cadute e spintoni".
I genitori hanno anche valutato la terapia laser, ma l'esperienza di altri pazienti, che hanno visto riformarsi il melanoma in forma più aggressiva dopo due anni, li ha convinti a proseguire con il trattamento chirurgico. In questa lunga battaglia, la famiglia Bortolotto può contare sull'affetto dei parenti, della gente comune e sul supporto dell'associazione Mauro Baschirotto di Longare, da trent'anni impegnata nel campo delle malattie rare. L'associazione, attraverso il suo Centro diagnostico riabilitativo extra ospedaliero, riconosciuto dalla Regione Veneto, si è impegnata ad avviare un progetto di ricerca specifico sul nevo congenito melanocitico gigante.
I melanomi dell'età pediatrica
Una Lotta Personale: Melanoma in Età Adulta e le Sue Implicazioni
Le sfide legate al melanoma non si limitano all'infanzia. La storia di Giada, una donna di 37 anni residente a Roma, illustra la lotta contro questa malattia in età adulta, evidenziando aspetti psicologici, emotivi e medici altrettanto complessi. La sua narrazione, condivisa in un forum online, offre una testimonianza toccante di resilienza e speranza.
Tutto ebbe inizio il 7 luglio 2022, quando, dopo aver ricevuto l'esito di un esame istologico, Giada si trovò di fronte alla parola "MELANOMA". La paura, la rabbia e la delusione la travolsero, specialmente considerando la recente perdita del padre per un carcinoma polmonare. Inizialmente cadde nello sconforto più totale, chiedendosi il perché di tale sofferenza. Tuttavia, le parole del suo compagno, Alessandro, furono un faro: "devi reagire non possiamo arrenderci, dobbiamo invecchiare insieme, voglio una vita lunga con te!". Questo amore le diede la forza di combattere.

La coppia si rivolse all'Istituto nazionale dei tumori Regina Elena IFO di Roma. Durante questo periodo, Giada scoprì di essere incinta. La felicità iniziale si trasformò in un dilemma straziante quando arrivò il secondo esito istologico, che confermò la presenza del melanoma, seppur declassificato in PT2 con margini puliti. La notizia della gravidanza sconvolse il medico, che capì immediatamente la gravità della situazione. Il dilemma era crudele: portare avanti la gravidanza avrebbe potuto mettere a rischio la sua vita, mentre interromperla significava rinunciare al sogno di diventare madre. Dopo giorni di profonda sofferenza e confronto con Alessandro, Giada prese la difficile decisione di interrompere la gravidanza, giudicata forse egoista, ma ritenuta la scelta meno dolorosa per tutti nel lungo termine. Il 10 agosto 2022, giorno dell'aborto farmacologico, fu il più doloroso della sua vita, un momento di profonda sconfitta.
Il 31 agosto 2022, Giada subì l'intervento di allargamento e la rimozione del linfonodo sentinella, che risultò negativo, indicando che il melanoma era ancora localizzato. Nonostante potesse fermarsi ai controlli semestrali, l'oncologo le suggerì una terapia sperimentale per prevenire recidive. I mesi successivi sembrarono promettenti, ma nell'aprile 2023, Giada avvertì un piccolo nodulo all'inguine sinistro. Nonostante l'iniziale sottovalutazione, il nodulo crebbe, diventando un'infiammazione dolorosa. L'esame istologico confermò la presenza di cellule maligne di melanoma: la prima metastasi.
Seguirono due interventi chirurgici per rimuovere la metastasi e, un mese dopo, lo svuotamento dei linfonodi della gamba sinistra, con la rimozione di 25 linfonodi. Giada iniziò la terapia TARGET, una terapia orale, e i controlli mensili procedevano bene, nonostante l'insorgenza di linfedema, un gonfiore dell'arto dovuto allo svuotamento dei linfonodi. Il suo umore migliorò, e iniziò a pensare alla possibilità di avere un bambino al termine della terapia.
Il 20 giugno 2024, Giada e Alessandro si sposarono. La serenità, tuttavia, durò poco. A settembre 2024, solo due mesi dopo aver concluso la terapia Target, notò una nuova pallina all'inguine sinistro. Inizialmente pensò a un pelo incarnito o a un lipoma, convinta che fosse impossibile una recidiva dato l'asportazione dei linfonodi. Purtroppo, un'ecografia confermò la presenza di una nuova metastasi, definita "Metastasi in Transit", localizzata sulla coscia. Si trattava di una cellula che, non avendo linfonodi disponibili, si era diffusa a livello cutaneo.
Fu subito organizzato un intervento chirurgico per la rimozione e la pulizia locale. Il chirurgo decise di asportare una maggiore quantità di tessuto dalla gamba per eliminare eventuali micrometastasi. L'intervento, durato sette ore il 6 novembre 2024, fu lungo e complesso, comportando la ricostruzione della coscia con pelle del ginocchio e circa 100 punti di sutura. Il periodo di convalescenza fu estremamente difficile, con l'impossibilità di muovere la gamba per un mese e mezzo, assistita costantemente da Alessandro.
Il 13 gennaio arrivò finalmente la risposta tanto attesa: ESENTE DA MALATTIA. Per la terza volta in tre anni, Giada era riuscita a sconfiggere il melanoma. Attualmente, sta seguendo un'immunoterapia con NIVOLUMAB, con infusioni ogni 28 giorni per un anno, al fine di prevenire ulteriori recidive. Nonostante la vittoria, Giada è consapevole che la guerra non è finita, ma spera che questa terapia le garantisca un periodo di tregua.
La sua esperienza è stata profondamente trasformativa. "La lotta contro il cancro ti cambia, cambia il modo in cui vedi la vita, spesso la si dà per scontato, non si gioisce per le piccole cose, ci si arrabbia per nulla. Io ero così, ero una persona che aveva indossato una maschera per non mostrare al mondo le proprie debolezze; ora, dopo il cancro, quella maschera l’ho tolta e le mie debolezze le mostro con orgoglio, perché fanno parte di me. La malattia mi ha reso più dura, non mi lascio più ferire dal giudizio altrui, io so quello che ho affrontato e so come ne sono uscita. Sono molto orgogliosa della donna che sono oggi, nonostante la mia guerra, non ho mai smesso di essere una donna indipendente e sicura di sé, mi guardo allo specchio e mi sorrido. piano. Sono una sopravvissuta, con un'immensa voglia di vivere e di sorridere. Sono una donna consapevole della propria forza, sono una donna segnata dal dolore, ma che ha imparato a rialzarsi ogni volta che tocca il fondo. Il mio motto è diventato: “occhi aperti e cuor leggero”."
Giada ha scelto di condividere la sua storia per lanciare un messaggio di speranza a chi combatte contro il male, sottolineando l'importanza di trovare sempre un motivo per lottare, per lei rappresentato dall'amore di suo marito. Ringrazia specialmente Alessandro, definito il suo coraggio, e l'intero ospedale IFO di Roma.
Aspetti Legali e Controversie: Il Caso di Giada Bortolotto (2007)
La vicenda di Giada Bortolotto, scomparsa nel 2007 all'età di 22 anni a causa di un melanoma, ha avuto anche un risvolto giudiziario, sollevando interrogativi sulla tempestività della diagnosi e sulla gestione medica. Un medico di base è stato rinviato a giudizio per omicidio colposo per colpa medica, mentre per un altro è stata richiesta l'archiviazione. I genitori della giovane si sono costituiti parte civile, chiedendo un risarcimento danni di 300.000 euro.
Secondo l'accusa, il medico di base, Giuseppe Spirlì, avrebbe sottovalutato la situazione iniziale. La giovane si era rivolta a lui nel luglio 2004 per un neo e uno strano gonfiore alla gamba. Il medico l'aveva inviata in pronto soccorso a Castelfranco per accertamenti, ma la gamba non era guarita e la situazione è peggiorata. Solo in un secondo momento è stato accertato il melanoma. L'accusa principale nei confronti del dottor Spirlì è di non aver eseguito gli accertamenti necessari alla diagnosi precoce. La prima udienza del processo è stata fissata per il 3 aprile.

Tuttavia, una consulenza di parte, affidata a un oncologo, ha parzialmente scagionato il medico, sostenendo che avesse disposto accertamenti approfonditi da eseguire in ospedale, facendo tutto ciò che era in suo potere. Secondo questa consulenza, il melanoma, anche se diagnosticato con largo anticipo, non avrebbe lasciato scampo alla vittima. È stato inoltre sottolineato come fosse compito dell'ospedale effettuare una biopsia sul neo e sul linfonodo sentinella, procedure non alla portata di un medico di base.
La vicenda è complessa e dibattuta, con diverse interpretazioni sulla responsabilità medica e sulla possibilità di una diagnosi precoce che avrebbe potuto cambiare l'esito della malattia. Il processo mira a fare chiarezza su queste responsabilità e a stabilire eventuali colpe. La morte di Giada Bortolotto, una giovane maestra d'asilo, ha profondamente scosso la comunità di Castello di Godego, evidenziando quanto sia cruciale la tempestività e l'accuratezza nella diagnosi delle patologie oncologiche.
Comprendere il Melanoma: Dalla Biologia alla Terapia
Il melanoma è un tumore maligno che origina dai melanociti, le cellule responsabili della produzione di melanina, il pigmento che conferisce colore alla pelle. Sebbene possa manifestarsi in diverse forme, il melanoma congenito melanocitico gigante è una variante rara caratterizzata da lesioni cutanee estese presenti alla nascita.
Fattori di Rischio e Cause:L'esposizione ai raggi ultravioletti (UV) del sole è il principale fattore di rischio per lo sviluppo del melanoma. Tuttavia, nel caso del melanoma congenito, la causa è legata a mutazioni genetiche che si verificano durante lo sviluppo fetale. La predisposizione genetica gioca anche un ruolo importante, con alcune famiglie che presentano una maggiore incidenza di questa malattia.
Sintomi e Diagnosi:Il melanoma si presenta spesso come un neo che cambia aspetto, colore, dimensione o forma, o come una nuova lesione cutanea. La regola ABCDE è uno strumento utile per riconoscere i potenziali segni di allarme:
- Asimmetria: una metà del neo è diversa dall'altra.
- Bordi irregolari: i margini sono frastagliati o sfumati.
- Colore disomogeneo: presenta diverse sfumature di marrone, nero, blu, rosso o bianco.
- Diametro: solitamente superiore a 6 millimetri, anche se può essere più piccolo.
- Evoluzione: il neo cambia aspetto nel tempo.
La diagnosi precoce è fondamentale e si basa sull'esame clinico della lesione e sulla dermatoscopia. In caso di sospetto, viene eseguita una biopsia per confermare la diagnosi e valutare lo stadio del tumore.

Stadiazione e Prognosi:La stadiazione del melanoma considera lo spessore del tumore (misurato in millimetri), la presenza di ulcerazioni, la conta dei linfonodi sentinella coinvolti e la presenza di metastasi a distanza. La prognosi dipende dallo stadio al momento della diagnosi; i melanomi in stadio precoce hanno un'altissima probabilità di guarigione, mentre quelli in stadio avanzato presentano una prognosi più riservata.
Opzioni Terapeutiche:Il trattamento del melanoma varia in base allo stadio della malattia:
- Chirurgia: È il trattamento principale per i melanomi in stadio iniziale. Consiste nell'asportazione chirurgica del tumore con un margine di tessuto sano circostante. Per il melanoma congenito gigante, la chirurgia è l'unica opzione terapeutica, ma richiede procedure complesse e multiple, come nel caso di Giada Bortolotto, che coinvolgono la rimozione di ampie aree di pelle e la ricostruzione tramite innesti cutanei.
- Terapia Adjuvante: Dopo l'intervento chirurgico per melanomi in stadio avanzato, possono essere utilizzate terapie aggiuntive per ridurre il rischio di recidiva. Queste includono immunoterapia (farmaci che stimolano il sistema immunitario a combattere le cellule tumorali) e terapie mirate (farmaci che bloccano specifici bersagli molecolari presenti nelle cellule tumorali).
- Immunoterapia: Farmaci come il Nivolumab, utilizzato da Giada, hanno rivoluzionato il trattamento del melanoma metastatico, offrendo nuove speranze ai pazienti.
- Terapie Mirate: Farmaci che agiscono su specifiche mutazioni genetiche (come BRAF e MEK) sono efficaci in una parte dei pazienti con melanoma.
- Radioterapia e Chemioterapia: Queste terapie sono meno utilizzate nel melanoma rispetto ad altri tumori, ma possono essere impiegate in casi selezionati.
La ricerca continua a fare passi da gigante nello sviluppo di nuove terapie e strategie diagnostiche, offrendo prospettive sempre più incoraggianti per i pazienti affetti da melanoma, anche nelle sue forme più complesse e rare.
tags: #giada #bortolotto #melanoma